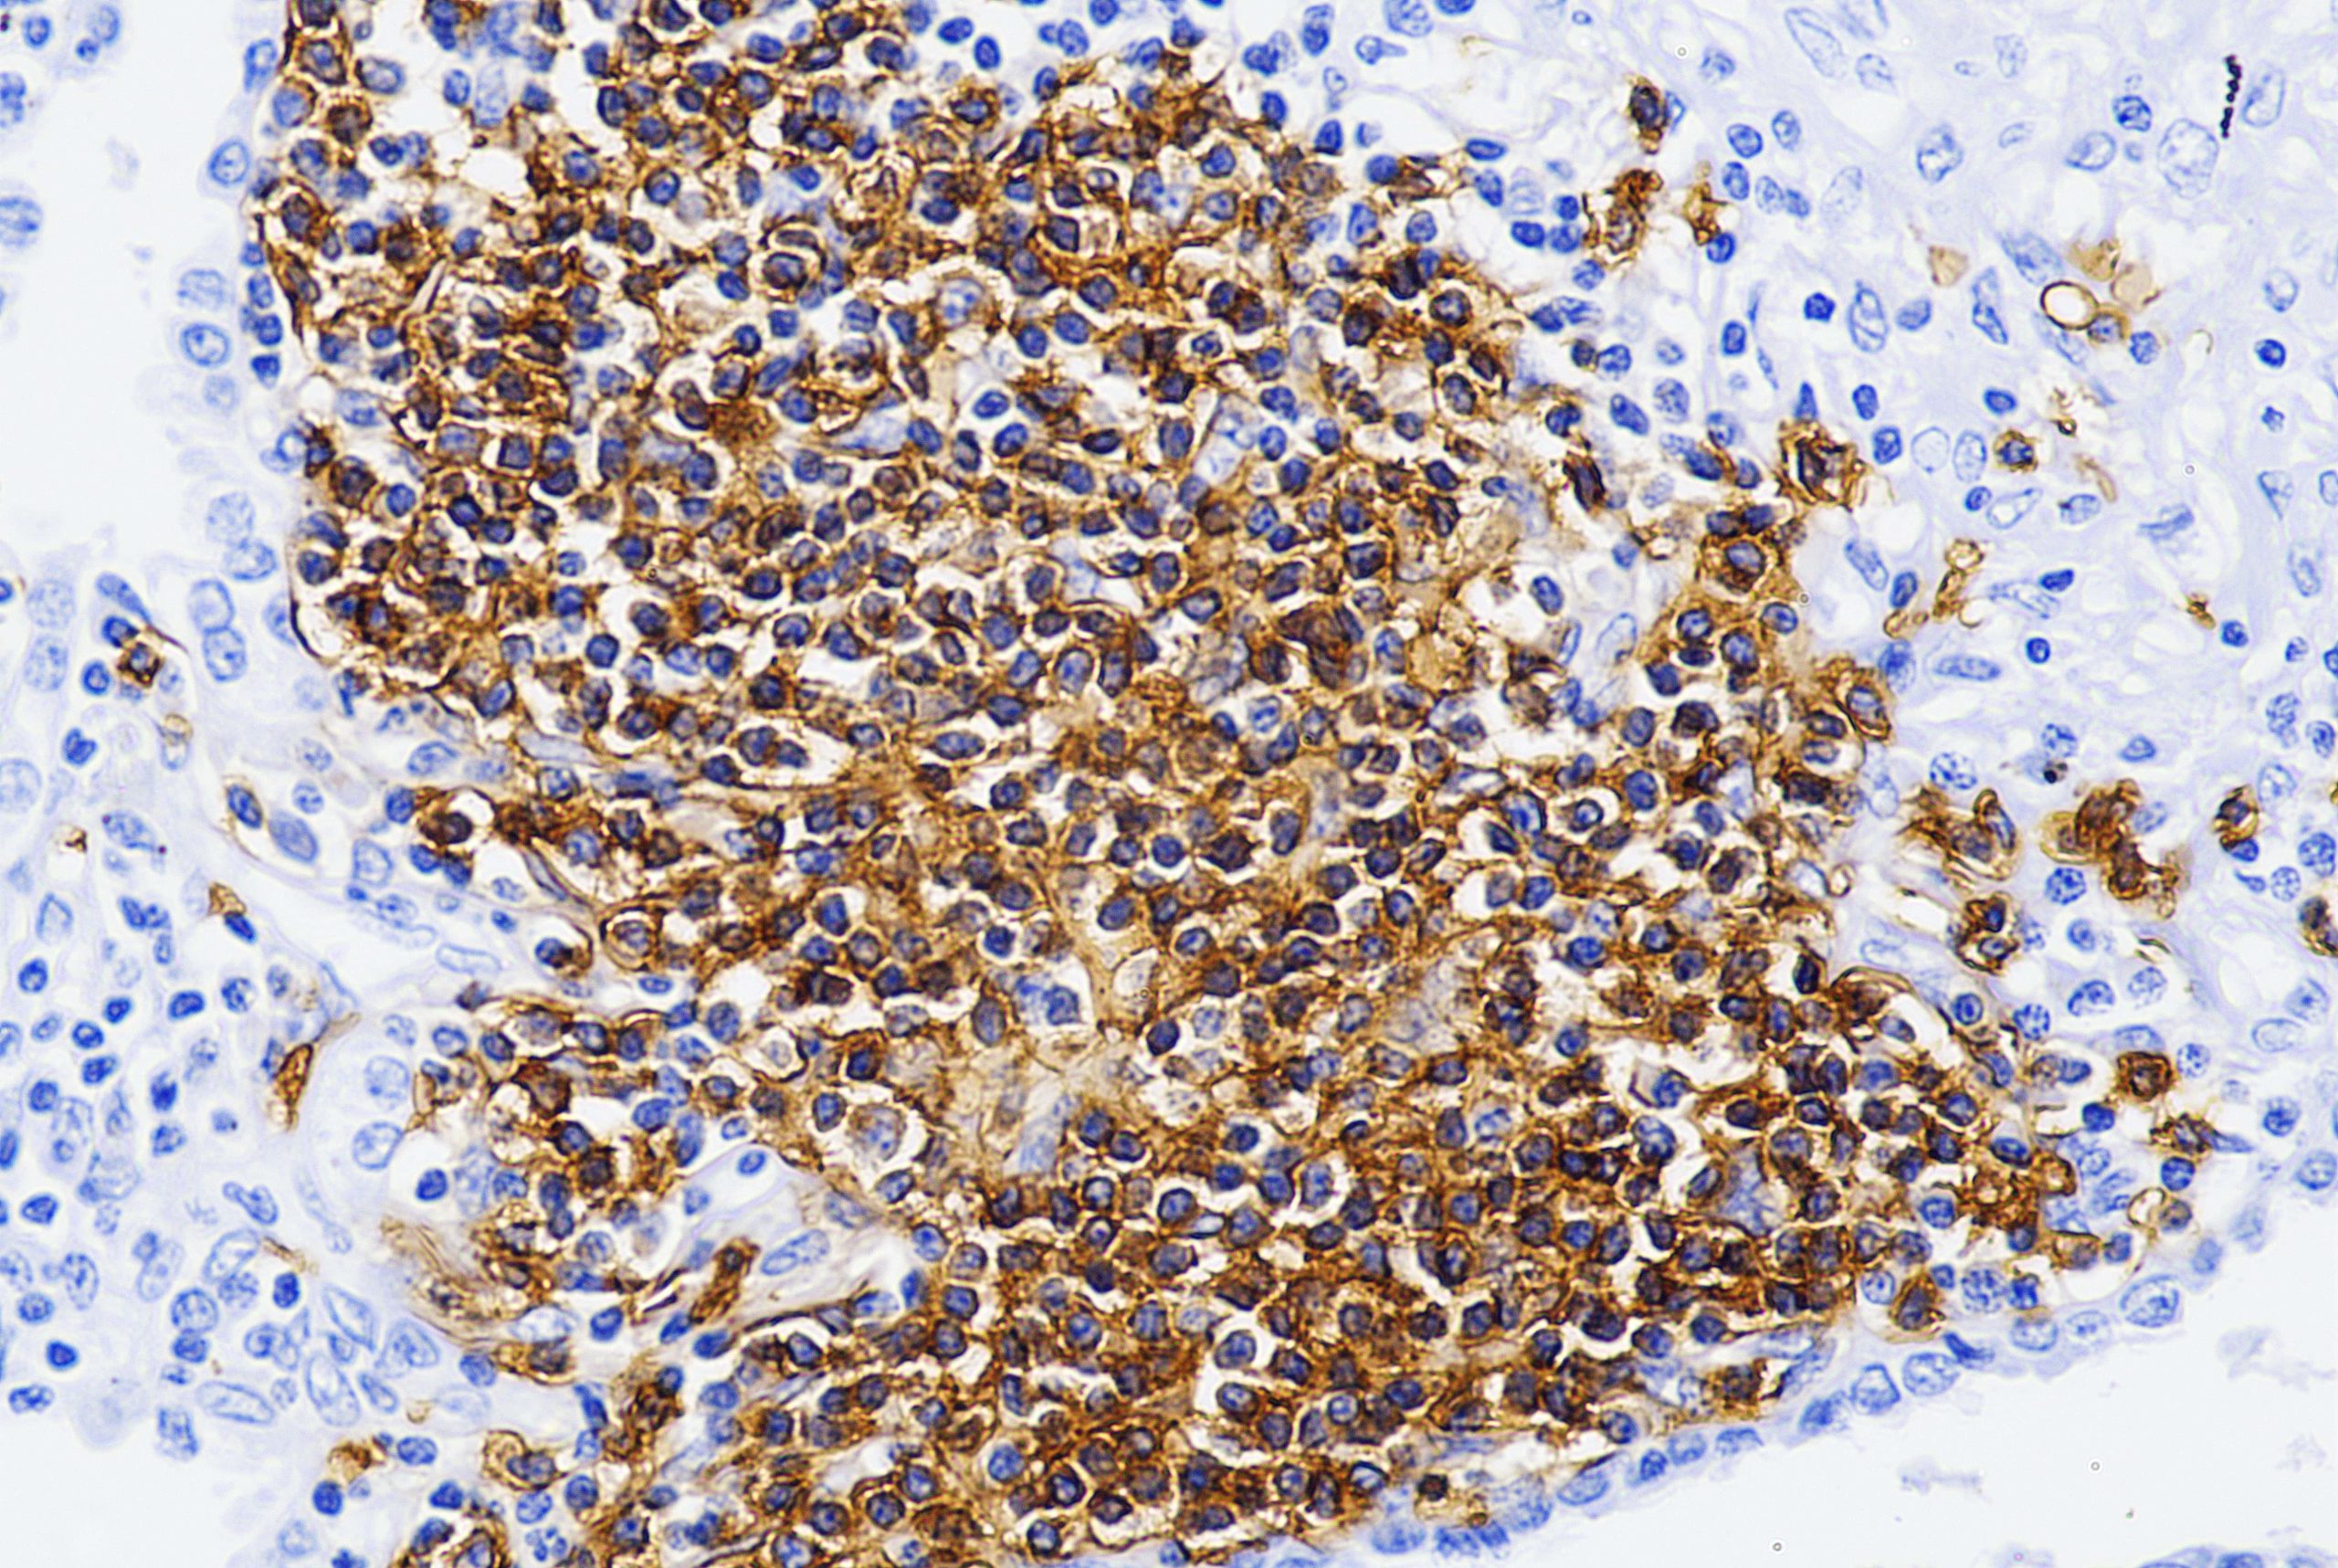
AM980

Anti-Kappa Light Chain [HP6053+L1C1]
There are two types of light chain in humans (Kappa (?) Light Chain and Lambda (?) Light Chain. Normally, the total Kappa to Lambda ratio is about 2:1 in serum, with a highly divergent ratio indicative of neoplasm. If one type of lightchain level is significantly higher than that of the other type, it indicates a malignant condition, such as B-cell lymphoma. This antibody is designed specific for Kappa Light Chain of Immunoglobulin, as a B cell marker. Detection of gene rearrangements and abnormal expression of Kappa Light Chain in immunoglobulin, are important methods in the diagnosis of B-cell lymphoma,? Plasma cell myeloma, and Reactive follicular hyperplasia. The most important role of the antibody would be in distinguishing atypical reactive follicular lymphoid hyperplasia from follicular lymphoma. In general, the neoplastic cells of follicle-like arrangement in extramedullary plasmacytoma and extracellular material are positive for Kappa Light Chain.
| Intended Use | IVD |
|---|---|
| Antibody Type | Monoclonal |
| Clone | HP6053+L1C1 |
| Source | Mouse |
| Tissue Type/Cancer Type | Tonsil |
| Pack | 0.5 mL – Manual – Concentrate, 1 mL – Manual – Concentrate, 6 mL – Manual – RTU, 50 Tests – Automation – Xmatrx, 100 Tests – Automation – i6000, 160 Tests – Automation – Xmatrx, 5 slides – Xmatrx, 5 slides – Manual, 50 tests – NanoVIP® |